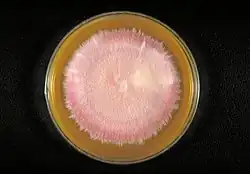

Agar Sabouraud

El agar Sabouraud (SDA) es un medio de cultivo que por sus características funciona como medio de enriquecimiento para hongos y que en caso de contener cloranfenicol u otro antibiótico, se convierte en un medio selectivo para los mismos. El medio contiene peptonas[1] y una elevada concentración de glucosa que favorece el crecimiento de los hongos sobre las bacterias. Es utilizado para el cultivo de hongos, especialmente dermatofitos, aunque también pueden desarrollarse en él cierto tipo de bacterias filamentosas tales como Nocardia.[2][3][4]
Fue utilizado por primera vez por Raymond Sabouraud en 1870. Más tarde Chester W. Emmons mejoró el medio acercando el pH al neutro (pH entre 5,5 y 6,0) y disminuyendo el nivel de glucosa para permitir el crecimiento de otros subcultivos de hongos.[5]
Composición típica
Contiene normalmente:[6]
Véase también
- Agar McConkey
- Agar sangre
- Agar chocolate
- Agar CLED
- Agar SDAY
Referencias
(en inglés)
- ↑ «Omnipresence of Microorganisms in the Environment». Archivado desde el original el 6 de octubre de 2008. Consultado el 24 de octubre de 2008.
- ↑ Sandven P, Lassen J (noviembre de 1999). «Importance of selective media for recovery of yeasts from clinical specimens». Journal of clinical microbiology 37 (11): 3731-2. PMC 85742. PMID 10523586.
- ↑ Guinea J, Peláez T, Alcalá L, Bouza E (diciembre de 2005). «Evaluation of Czapeck agar and Sabouraud dextrose agar for the culture of airborne Aspergillus conidia». Diagnostic microbiology and infectious disease 53 (4): 333-4. PMID 16263232. doi:10.1016/j.diagmicrobio.2005.07.002.
- ↑ About Modified Sabouraud Agar
- ↑ History and Expected Growth
- ↑ University of Sydney, Recipes.
Enlaces externos
(en inglés)
- Definition from Online medical Dictionary (enlace roto disponible en Internet Archive; véase el historial, la primera versión y la última).
- National Standard Method Archivado el 6 de noviembre de 2010 en Wayback Machine.
- Images of Bacteria Grown on Sabouraud Agar
- Irradiated Sabouraud Agar